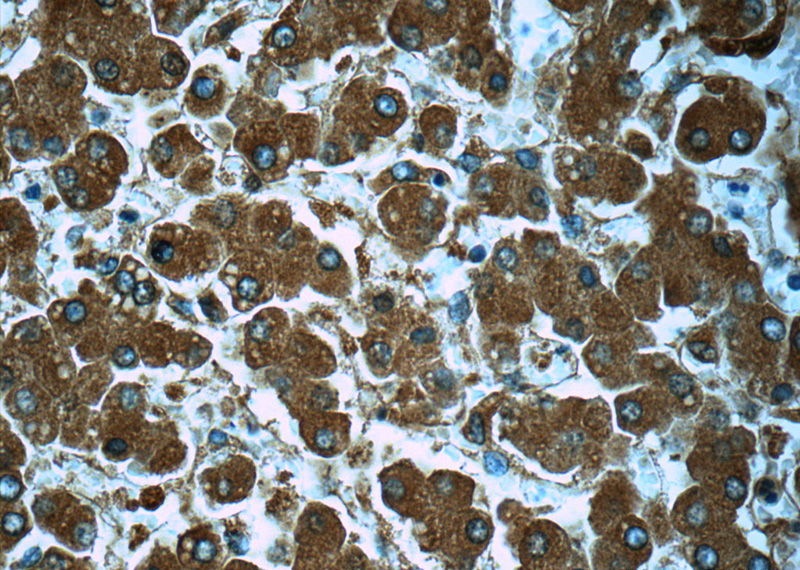

-
Product Name
alpha 1 Antichymotrypsin / AACT antibody
- Documents
-
Description
alpha 1 Antichymotrypsin / AACT Rabbit Polyclonal antibody. Positive WB detected in human blood tissue, COLO 320 cells, human colon tissue. Positive IHC detected in human liver tissue, human spleen tissue. Observed molecular weight by Western-blot: 44-70 kDa
-
Tested applications
ELISA, IHC, WB
-
Species reactivity
Human; other species not tested.
-
Alternative names
A1 Antichymotrypsin antibody; AACT antibody; ACT antibody; Alpha 1 antichymotrypsin antibody; GIG24 antibody; GIG25 antibody; Serpin A3 antibody; SERPINA3 antibody
-
Isotype
Rabbit IgG
-
Preparation
This antibody was obtained by immunization of alpha 1 Antichymotrypsin / AACT recombinant protein (Accession Number: NM_001384672). Purification method: Antigen affinity purified.
-
Clonality
Polyclonal
-
Formulation
PBS with 0.02% sodium azide and 50% glycerol pH 7.3.
-
Storage instructions
Store at -20℃. DO NOT ALIQUOT
-
Applications
Recommended Dilution:
WB: 1:200-1:2000
IHC: 1:20-1:200
-
Validations

human blood tissue were subjected to SDS PAGE followed by western blot with Catalog No:107861(SERPINA3,AACT antibody) at dilution of 1:500

Immunohistochemistry of paraffin-embedded human liver tissue slide using Catalog No:107861(SERPINA3,AACT Antibody) at dilution of 1:50
Immunohistochemistry of paraffin-embedded human liver tissue slide using Catalog No:107861(SERPINA3,AACT Antibody) at dilution of 1:50
-
Background
Human SerpinA3, also known as Alpha 1-antichymotrypsin (AACT), is a member of the serine protease inhibitor class, and is a plasma alpha globulin glycoprotein which increases in the blood during the inflammatory process. SerpinA3, is also an inhibitor of neutrophil cathepsin G, mast cell chymases and pancreatic chymotrypsin. SerpinA3 is produced primarily in the liver, and is identified as an acute-phase inflammatory protein. SerpinA3 deficiency has been associated with liver disease. SerpinA3 has also been implicated in the pathology of a number of devastating human diseases including chronic obstructive pulmonary disease (COPD), Parkinson’s disease (PD), Alzheimer’s disease (AD), Stroke, Cystic Fibrosis, Cerebral Haemorrhage and Multiple System Atrophy.
Related Products / Services
Please note: All products are "FOR RESEARCH USE ONLY AND ARE NOT INTENDED FOR DIAGNOSTIC OR THERAPEUTIC USE"
